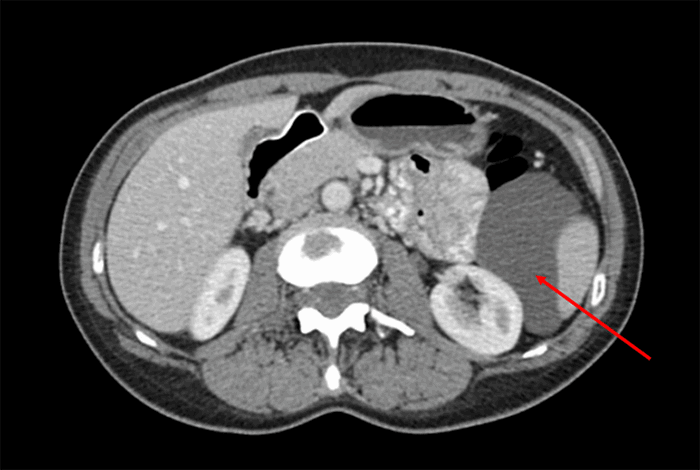

Benign Multicystic Peritoneal Mesothelioma Within the Retroperitoneum
January 11, 2022
Abstract
Background
A female patient presented with symptomatic, progressively enlarging, benign multicystic peritoneal mesothelioma (BMPM).
Summary
Our patient is a 46-year-old female with a past medical history of endometriosis and multiple gynecological surgeries who presented with continuous pressure-like and burning pain in the left abdomen. Due to her progression of symptoms, surgical management was pursued. Prior imaging studies demonstrated the presence of a hypodense, loculated fluid collection in the left paracolic gutter that increased in size. Gross examination of the removed specimen found a thin-walled cystic mass with multiple attached daughter cysts. Pathology confirmed findings consistent with BMPM.
Conclusion
BMPM is a rare clinical entity that occurs most frequently in women with a history of gynecologic pathology or abdominopelvic surgery. Mass effect can cause symptoms of discomfort and pain that necessitate operative management. Further, there are reports of BMPM undergoing malignant transformation, but the actual risk of malignancy is unknown.
Key Words
benign multicystic peritoneal mesothelioma; retroperitoneum
Case Description
Benign multicystic peritoneal mesothelioma (BMPM) is a rare, benign cystic tumor arising from the peritoneum. It typically occurs in women with a history of abdominal surgery or other inflammatory conditions within the pelvis.
Our patient is a 46-year-old female with a medical history of endometriosis, right ovarian cyst status-post right oophorectomy, fibroid uterus status-post myomectomy, and subsequent vaginal hysterectomy who presented to our clinic in 2018 with continuous pressure-like and burning pain in the left abdomen and flank. She denied any other systemic symptoms. Physical exam revealed a soft, non-distended abdomen with tenderness to deep palpation in the left abdomen without rebound or guarding.
In 2014 she underwent computed tomography (CT) during her workup for pain and vaginal bleeding at an outside hospital. This imaging confirmed uterine fibroids in addition to a misidentified "left renal cyst." The cyst measured 4.8 cm × 2.9 cm and had multiple septations. Four years later, the patient had worsening abdominal discomfort and underwent workup with reimaging of her abdomen. An abdominal/pelvis CT scan (Figure 1) again demonstrated the presence of a hypodense, septate fluid collection in the left upper abdomen. The lesion had increased in size and was approximately 9.8 cm in the greatest dimension. The colonoscopic evaluation did not demonstrate any large bowel involvement. Subsequent CT-guided core needle biopsy revealed proteinaceous fluid with few inflammatory cells.
Figure 1. CT image-Axial View. Published with Permission

Hypodense fluid collection measuring approximately 84 mm in the AP dimension within the retroperitoneum abutting spleen, left kidney, pancreatic tail, and descending colon
At this time, the patient was referred to our general surgery clinic for evaluation. Given the increasing size of the lesion and worsening abdominal pain, the decision was made to proceed with an exploratory laparotomy. An effort was made to resect the visible lesion and avoid the rupture or spillage of cystic content. A pink-tan, smooth, intact, thin-walled cystic mass (Figure 2) was removed. The mass weighed 136 grams, measured 9.5 cm × 8.1 cm × 4.0 cm, and had multiple attached daughter cysts (0.2 cm‒0.7 cm). All cysts contained a thin, clear fluid with no solid areas identified. The histologic examination was consistent with BMPM, showing cysts lined with mesothelial cells and foci of fibroblastic/mesothelial proliferation along with numerous blood vessels within the stroma (Figure 3).
Figure 2. Gross Specimen Demonstrating a Smooth, Intact, Thin-Walled, Pink Cyst. Published with Permission
Specimen measured 9.5 cm × 8.1 cm × 4.0 cm, with an area of smaller attached thin-walled pink-tan cystic structures measuring 0.2 to 0.7 cm in greatest dimension
Figure 3. Histologic Images. Published with Permission

A) Demonstrates AE 1-3 staining at 200x magnification; B) Demonstrates calretinin staining at 200x magnification; C) Demonstrates WT1 staining at 100x magnification
A plan was made for follow-up in the clinic with surveillance imaging at 6 months and 12 months from surgery. At six months, the patient had improved abdominal symptoms, and CT imaging did not demonstrate any recurrence of cystic lesions consistent with BMPM.
Discussion
BMPM remains a rare entity with fewer than 200 cases reported in the literature. The estimated incidence is 0.15/100,000 cases annually.1,2 Typically, BMPM occurs in women with a history of endometriosis, pelvic surgery, and pelvic inflammatory disease. It is often clinically silent but can cause symptomatic displacement of abdominal contents.3–5
The pathogenesis of BMPM is unknown, but there are several proposed hypotheses.6,7 The most widely accepted inflammatory process leads to chronic irritation of the peritoneum with reactive hyperplasia, cystic formation, and dysplastic transformation of the mesothelial cells.4,6 Other proposed etiologies include a slowly progressing neoplastic process of the peritoneal serosa and hormonal influence on peritoneal mesothelial cells. This hormonal origin is suggested due to BMPM's higher incidence in women of reproductive age, rare development following oophorectomy, and responsiveness to hormone treatments.8
The symptoms of BMPM are vague and associated with mass effects on other organs. Physical examination may find abdominal distention, tenderness, and palpable masses within the abdomen or pelvis.9,10 Masses within the retroperitoneum may be more challenging to identify with a physical examination based on their deeper anatomic location.4
Imaging with ultrasound (US) and CT can be useful tools in identifying cystic formations but will not differentiate BMPM from other similar disease processes. CT scans can provide details about the location and extent of the disease. Lesions will usually demonstrate thin-walled, multiloculated, multicystic masses. Magnetic resonance imaging can be considered for further surgical planning and cyst characterization but is often not necessary.11 The differential diagnoses for these cystic lesions are broad and can include lymphangioma, malignant peritoneal mesothelioma (MPM), loculated ascites, pseudomyxoma peritonei, and cystadenoma of the ovary.
Definitive diagnosis of BMPM is made via evaluation of cyst aspirate and histological examination of cyst walls. BMPM is composed of thin-walled cysts lined by single-layered mesothelial cells without atypia and filled with serous fluid. Confirmatory testing can be achieved with positive immunohistochemical staining of mesothelial cells for calretinin and WT1.10,12
En bloc surgical resection with excision of localized cysts is both diagnostic and therapeutic. Future recurrence is noted in 41–50 percent of cases and is more frequent in women.13,14 Multiple adjuvant treatments have been proposed, including heated intraperitoneal chemotherapy (HIPEC) and hormonal therapy. HIPEC is utilized with debulking procedures in the management of MPM, and case reports have demonstrated possible improvement in recurrence rates of BMPM.15 Long-acting gonadotropin-releasing hormone and estrogen receptor modulator treatments have reduced volume and growth in limited case studies.16,17 None of these treatments have been validated in a randomized control trial due to the infrequency of this disease. Surveillance with CT imaging is recommended following surgical excision; however, no established guidelines have been determined.
Conclusion
This case highlights the occurrence of BMPM among women with prior pelvic inflammatory conditions and demonstrates the possibility for growth within the retroperitoneum. While radiographic imaging is important for evaluating this disease, diagnoses are made by pathologic evaluation of resected tissue.
Lessons Learned
BMPM is a rare clinical entity, and surgical management is the standard treatment. Malignant transformation is rare but has been reported in multiple cases. Recurrence is common, and patients should be followed with serial imaging.
Authors
Grunvald MWa; Kuhn Ra; Webb Sb; Qureshi JSc
Author Affiliations
- Department of Surgery, Rush University Medical Center, Chicago, IL 60612
- Department of Pathology, University of Illinois at Chicago, Chicago, IL 60612
- Family Healthcare Network Memorial Hospital, Freeport, IL 61032
Corresponding Author
Miles W. Grunvald, MD
Department of Surgery
Rush University Medical Center
1653 W. Congress Parkway, 7th Floor Jelke
Chicago, IL 60612
Phone: (802) 999-6439
E-mail: miles_w_grunvald@rush.edu
Disclosure Statement
The authors have no conflicts of interest to disclose.
Funding/Support
The authors have no financial relationships or in-kind support to disclose.
Received: September 20, 2019
Revision Received: May 27, 2020
Accepted for Publication: September 29, 2020
References
- Lee CE, Agrawal A. Remote recurrence of benign multicystic peritoneal mesothelioma. J Obstet Gynaecol Can. 2017;39(11):1042-1045. doi:10.1016/j.jogc.2017.04.038
- Snyder JA, Carman R Jr, Aggon AA, Cardinale JP. Benign multicystic peritoneal mesothelioma: A rare case presenting as pneumoperitoneum and pneumotosis intestinalis. J Gastrointest Oncol. 2011;2(1):55-58. doi:10.3978/j.issn.2078-6891.2010.026
- Bakhshi GD, Wankhede KR, Tayade MB, Bhandarwar AH, Gore ST, Choure DD. Retroperitoneal approach for recurrent benign multicystic peritoneal mesothelioma. Clin Pract. 2013;3(1):e3. Published 2013 Jan 25. doi:10.4081/cp.2013.e3
- Safioleas MC, Constantinos K, Michael S, Konstantinos G, Constantinos S, Alkiviadis K. Benign multicystic peritoneal mesothelioma: a case report and review of the literature. World J Gastroenterol. 2006;12(35):5739-5742. doi:10.3748/wjg.v12.i35.5739
- Villaschi S, Autelitano F, Santeusanio G, Balistreri P. Cystic mesothelioma of the peritoneum. A report of three cases. Am J Clin Pathol. 1990;94(6):758-761. doi:10.1093/ajcp/94.6.758
- Occhionorelli S, Tartarini D, Pascale G, Maccatrozzo S, Stano R, Vasquez G. Benign multicystic mesothelioma of peritoneum complicating acute appendicitis in a man: a case report. J Med Case Rep. 2016;10:44. Published 2016 Feb 27. doi:10.1186/s13256-016-0826-6
- Lari F, Castelli G, Bragagni G. Mesotelioma multicistico peritoneale benigno [Benign multicystic peritoneal mesothelioma. A case report]. Recenti Prog Med. 2012;103(2):66-68. doi:10.1701/1045.11388
- Jerbi M, Hidar S, Ziadi S, Khairi H. Benign multicystic peritoneal mesothelioma. Int J Gynaecol Obstet. 2006;93(3):267-268. doi:10.1016/j.ijgo.2006.03.013
- Khurram MS, Shaikh H, Khan U, et al. Benign multicystic peritoneal mesothelioma: a rare condition in an uncommon gender. Case Rep Pathol. 2017;2017:9752908. doi:10.1155/2017/9752908
- Wang TB, Dai WG, Liu DW, Shi HP, Dong WG. Diagnosis and treatment of benign multicystic peritoneal mesothelioma. World J Gastroenterol. 2013;19(39):6689-6692. doi:10.3748/wjg.v19.i39.6689
- Lee R, Tong A, Kurtis B, Gilet AG. Benign multicystic peritoneal mesothelioma: AIRP best cases in radiologic-pathologic correlation. Radiographics. 2016;36(2):407-411. doi:10.1148/rg.2016150157
- Gussago S, Spina P, Guerra A. Benign multicystic peritoneal mesothelioma (BMPM) as a rare cause of abdominal pain in a young male: case report and review of the literature. J Surg Case Rep. 2019;2019(3):rjz057. Published 2019 Mar 13. doi:10.1093/jscr/rjz057
- Canu GL, Medas F, Columbano G, et al. Benign multicystic peritoneal mesothelioma in a male patient with previous Wilms' tumor: a case report and review of the literature. Case Rep Surg. 2018;2018:4324986. Published 2018 Aug 1. doi:10.1155/2018/4324986
- Meşină C, Dumitrescu TV, Mogoantă SŞ, et al. An unusual cause of acute surgical abdomen: benign multicystic peritoneal mesothelioma associated with adenomatous tumor. Rom J Morphol Embryol. 2018;59(3):971-976.
- Baratti D, Kusamura S, Sironi A, et al. Multicystic peritoneal mesothelioma treated by surgical cytoreduction and hyperthermic intra-peritoneal chemotherapy (HIPEC). In Vivo. 2008;22(1):153-157.
- Letterie GS, Yon JL. Use of a long-acting GnRH agonist for benign cystic mesothelioma. Obstet Gynecol. 1995;85(5 Pt 2):901-903. doi:10.1016/0029-7844(94)00431-c
- Letterie GS, Yon JL. The antiestrogen tamoxifen in the treatment of recurrent benign cystic mesothelioma. Gynecol Oncol. 1998;70(1):131-133. doi:10.1006/gyno.1998.5031